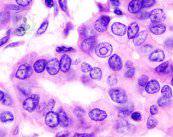
cancer-de-tiroides-enfermedad-de-origen-desconocido-parte-1 imagen de artículo

Cáncer de tiroides: enfermedad de origen desconocido (Parte 1)
El cáncer de tiroides tiene varios tipos entre los que se encuentran el carcinoma de células papilares, el de células foliculares y el de células medulares. Sus causas son desconocidas pero se asocia a una exposición previa a altas dosis de radiación.